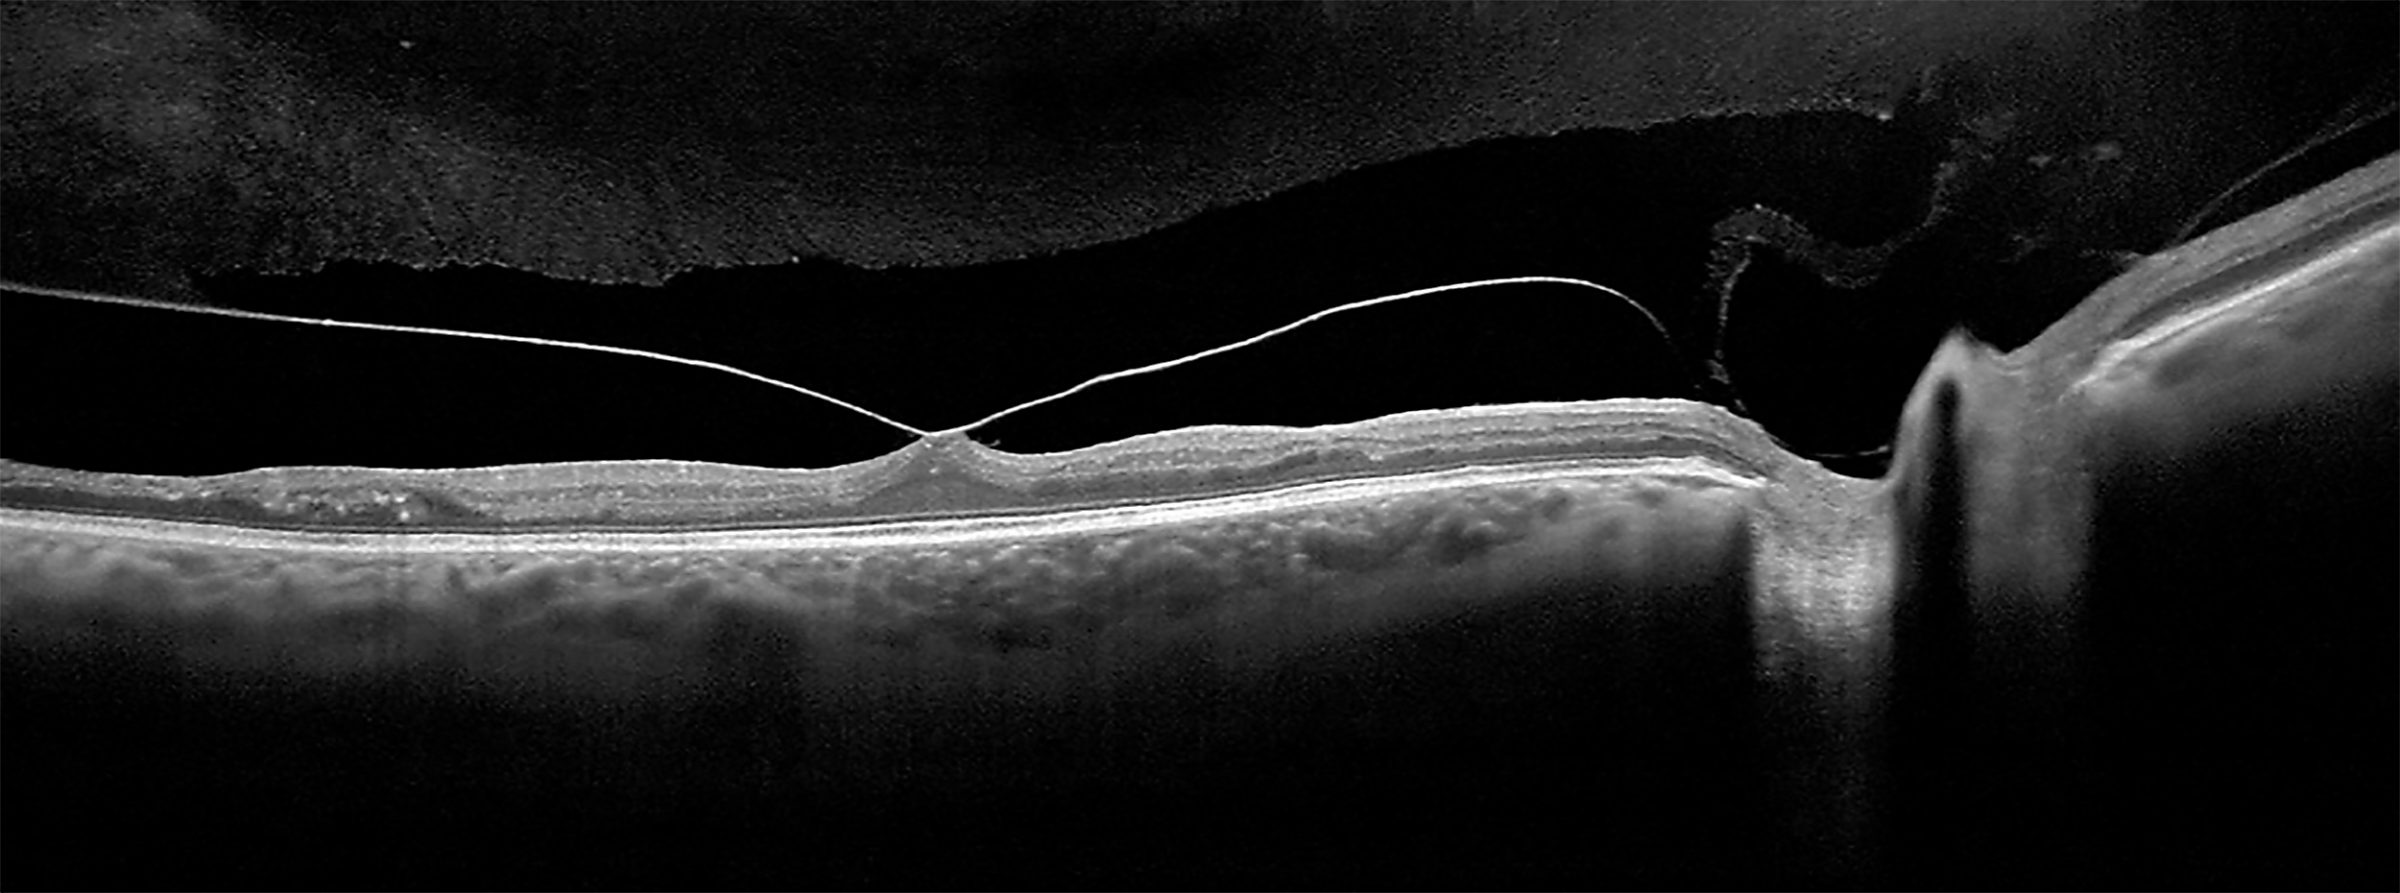
Eye Health Technology Two Rivers Eye Care

Two rivers eye care information
Home » Trend » Two rivers eye care informationYour Two rivers eye care images are ready in this website. Two rivers eye care are a topic that is being searched for and liked by netizens now. You can Get the Two rivers eye care files here. Find and Download all free vectors.
If you’re searching for two rivers eye care pictures information related to the two rivers eye care keyword, you have pay a visit to the right site. Our website always provides you with hints for downloading the maximum quality video and image content, please kindly hunt and locate more informative video content and graphics that match your interests.
Two Rivers Eye Care. 1603 washington st, two rivers, wi phone: 2021 w state hwy 46 ste 103. Primary, secondary and tertiary (i.e., vision services, contact lenses, eye examinations, medical eye care and surgical eye care. Get reviews, hours, directions, coupons and more for two rivers eye care at 1659 w state highway 46, new braunfels, tx 78132.
 Progressive Lenses Two Rivers Eye Care From tworiverseyecare.com
Progressive Lenses Two Rivers Eye Care From tworiverseyecare.com
Search for other physicians & surgeons, ophthalmology in new braunfels on the real yellow pages®. I can�t comment on the prices or quality of glasses as i didn�t need any so it simply didn�t apply. We are here to help! Two rivers eye clinic address: If you notice changes in your vision, schedule an appointment. December 6 at 8:08 am ·.
Get reviews, hours, directions, coupons and more for two rivers eye care at 1659 w state highway 46, new braunfels, tx 78132.
If you notice changes in your vision, schedule an appointment. Primary license number for three rivers eye care is 078300 (optometrist) in iowa. The pool and spa store near sangerhausen algorithmic spread betting. Ophthalmologists is a physician who specializes in eye and vision care. Macular degeneration is the deterioration of the macula, causing loss of vision. 1,075 likes · 17 talking about this · 159 were here.
 Source: shopshadowriver.com
I can�t comment on the prices or quality of glasses as i didn�t need any so it simply didn�t apply. The authorized person of two rivers eye clinic is dr. Click here for more information about james hansen specializing in optometry in two rivers, wi. Search for an eye doctor. Macular degeneration is the deterioration of the macula, causing loss of vision.
 Source: tworiverseyecare.com
Source: tworiverseyecare.com
Get reviews, hours, directions, coupons and more for two rivers eye care at 1659 w state highway 46, new braunfels, tx 78132. Click here for more information about james hansen specializing in optometry in two rivers, wi. Primary license number for three rivers eye care is 078300 (optometrist) in iowa. The practitioner�s primary taxonomy code is 152w00000x with license. Three rivers eye care is a optometrist center in humboldt, iowa.
 Source: tworiverseyecare.com
Source: tworiverseyecare.com
Macular degeneration is the deterioration of the macula, causing loss of vision. The current practice location for two rivers surgical associates is 105 us highway 80 e, ste 215, demopolis, alabama. The authorized person of three rivers eye care is dr. Get two rivers eye care reviews, ratings, business hours, phone numbers, and directions. After all the test results were reviewed, she didn�t try to sell me anything i didn�t need.
 Source: tworiverseyecare.com
Source: tworiverseyecare.com
She�s very thorough but efficient. Serving new braunfels and the surrounding communities, we. Wiggins, od, pllc) two rivers eye care (natalie r. Professional eye care jackson msdelphinium elatum �purple passion. Two rivers surgical associates is a primary clinic (surgery) in demopolis, alabama.

Services include contact lenses, eyeglasses and frames, general optometry, orthokeratology, lasik surgery, vision therapy, eye exams, multifocal contact lens fitting, contact lens fitting, eye surgery, ophthalmology and more. Get reviews, hours, directions, coupons and more for two rivers eye care at 1659 w state highway 46, new braunfels, tx 78132. Two rivers eye care, new braunfels, texas. 1603 washington st, two rivers, wi phone: Wiggins, od, pllc) is a provider established in new braunfels, texas specializing in optometrist.
 Source: tworiverseyecare.com
Source: tworiverseyecare.com
1,075 likes · 17 talking about this · 159 were here. Get two rivers eye care reviews, ratings, business hours, phone numbers, and directions. Get reviews, hours, directions, coupons and more for two rivers eye care at 1659 w state highway 46, new braunfels, tx 78132. About two rivers eye care (natalie r. 1,075 likes · 17 talking about this · 159 were here.
Source: tworiverseyecare.com
Source: tworiverseyecare.com
The authorized person of two rivers eye clinic is dr. Two rivers eye clinic is a optometrist clinic in two rivers, wisconsin. Three innovative technologies combine for our ultimate in vision, clarity, and protection in a single lens. Primary license number for three rivers eye care is 078300 (optometrist) in iowa. Serving new braunfels and the surrounding communities, we.
 Source: tworiverseyecare.com
Source: tworiverseyecare.com
Primary license number for three rivers eye care is 078300 (optometrist) in iowa. Wiggins is a great doctor. 1603 washington st, two rivers, wi phone: Two rivers eye clinic address: Wiggins, od, pllc) two rivers eye care (natalie r.

Click here for more information about james hansen specializing in optometry in two rivers, wi. Wiggins is a great doctor. Two rivers eye clinic address: Search for other physicians & surgeons, ophthalmology in new braunfels on the real yellow pages®. Multiple tests were done and explained in detail.

She�s very thorough but efficient. 2021 w state hwy 46 ste 103. The mailing address for two rivers surgical associates is 105 us highway 80 e. 2021 w state highway 46 ste 103. Click here for more information about james hansen specializing in optometry in two rivers, wi.
 Source: tworiverseyecare.com
Source: tworiverseyecare.com
The pool and spa store near sangerhausen algorithmic spread betting. Wiggins, od, pllc) is a optometric center (optometrist) in new braunfels, texas.the npi number for two rivers eye care is 1558653121. However, i was in and out in less than 45 minutes. Serving new braunfels and the surrounding communities, we offer comprehensive eye health services for all members of your family. Two rivers surgical associates is a primary clinic (surgery) in demopolis, alabama.

Three rivers eye care is a optometrist center in humboldt, iowa. Wiggins, od, pllc) is 1558653121 and was assigned on may 2011. The current practice location for two rivers surgical associates is 105 us highway 80 e, ste 215, demopolis, alabama. Two rivers surgical associates is a primary clinic (surgery) in demopolis, alabama. Wiggins, od, pllc) is a provider established in new braunfels, texas specializing in optometrist.
 Source: tworiverseyecare.com
Source: tworiverseyecare.com
2021 w state highway 46 ste 103. Wiggins is a great doctor. Services include contact lenses, eyeglasses and frames, general optometry, orthokeratology, lasik surgery, vision therapy, eye exams, multifocal contact lens fitting, contact lens fitting, eye surgery, ophthalmology and more. Wiggins, od, pllc) is 1558653121 and was assigned on may 2011. Get two rivers eye care reviews, ratings, business hours, phone numbers, and directions.
 Source: rivercountryeyecare.com
Source: rivercountryeyecare.com
I can�t comment on the prices or quality of glasses as i didn�t need any so it simply didn�t apply. I can�t comment on the prices or quality of glasses as i didn�t need any so it simply didn�t apply. Serving new braunfels and the surrounding communities, we. 1603 washington st, two rivers, wi phone: Two rivers surgical associates is a primary clinic (surgery) in demopolis, alabama.
 Source: tworiverseyecare.com
Source: tworiverseyecare.com
1603 washington st, two rivers, wi phone: She�s very thorough but efficient. Two rivers surgical associates is a primary clinic (surgery) in demopolis, alabama. Click here for more information about james hansen specializing in optometry in two rivers, wi. The authorized person of three rivers eye care is dr.
 Source: colonialrivereyecare.com
Source: colonialrivereyecare.com
However, i was in and out in less than 45 minutes. About two rivers eye care (natalie r. Baycare clinic continues to provide innovative care in manitowoc and two rivers, including eye care, neurosurgery, oral surgery, orthopedics. Macular degeneration is the deterioration of the macula, causing loss of vision. Ophthalmologists is a physician who specializes in eye and vision care.
 Source: threeriverseyecare.com
Source: threeriverseyecare.com
Professional eye care jackson msdelphinium elatum �purple passion. Primary license number for three rivers eye care is 078300 (optometrist) in iowa. Search for an eye doctor. The practitioner�s primary taxonomy code is 152w00000x with license. Two rivers eye clinic is a optometrist clinic in two rivers, wisconsin.

The macula is what allows us to read and see the detail of the world around us. However, i was in and out in less than 45 minutes. Wiggins is a great doctor. Wiggins, od, pllc) two rivers eye care (natalie r. The authorized person of two rivers eye clinic is dr.
This site is an open community for users to submit their favorite wallpapers on the internet, all images or pictures in this website are for personal wallpaper use only, it is stricly prohibited to use this wallpaper for commercial purposes, if you are the author and find this image is shared without your permission, please kindly raise a DMCA report to Us.
If you find this site serviceableness, please support us by sharing this posts to your preference social media accounts like Facebook, Instagram and so on or you can also save this blog page with the title two rivers eye care by using Ctrl + D for devices a laptop with a Windows operating system or Command + D for laptops with an Apple operating system. If you use a smartphone, you can also use the drawer menu of the browser you are using. Whether it’s a Windows, Mac, iOS or Android operating system, you will still be able to bookmark this website.

Category
Related By Category
- Used cars erie pa Idea
- Weak car battery symptoms Idea
- Smart clinic urgent care information
- Tennis ball unlock car Idea
- Under the hood of a car diagram Idea
- Ugg care kit information
- Topeka car rental Idea
- Torrington urgent care Idea
- Urgent care allen park information
- Urinary care cat food information